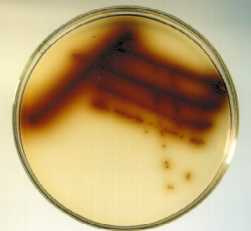
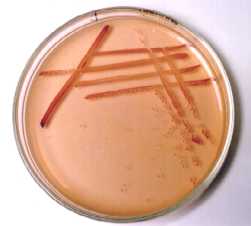
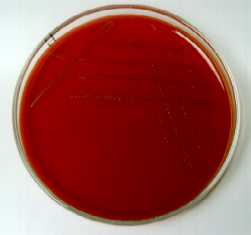
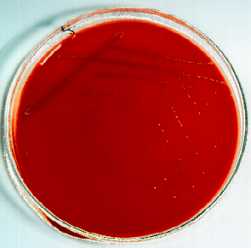
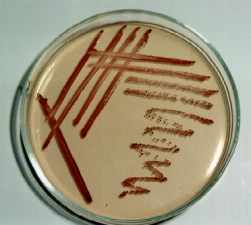

| Prosinec 3.12.2001 |
10:55 - fetka fretka |
Wejkend? Bylo to hustý, zpětně bych řekl dosti dekadentní. Nechce se mi zatím psát. Moc zážitků, moc prožitků. Balet mezi životem a smrtí. Obrazně. Naštěstí....
| 04.12.2001 |
09:25 - osypaná osika oslizla osla |
Na ja hjumaníci. Taxem se vyzvrátil nazpět do reality.
Nevím jak a kdo s říká co chce, ale nejpíš oceníte při svém veškerém smažení tento webovej odkaz, kterej Vám připomene, že byste neměli zapomenout vzít si pilulku.
Je na to čas. Odstávat a klepat se jako osika v absolutním bezvětří. Osamocená na vrcholku kopce, připadá si jako ve špatným filmu. Ve filmu, kde jsou osypaný osiky právě na takovejch zasranejch kopcích a klepaj se při očekávání nečekaného. Nedočkaj se, protože tohle je fakt zasraně blbej film. V blbejch filmech se věci dějí naprosto tak, jak se normálně odehrávat nemůžou. Ví to, ale nemůže se pohnout.
Blik. Cvak. Země za zrcadlem. Sedí u stěny a kouká do dveří. Nejsou to ledajaký dveře. Můžete jimi projít do země za skleněnou plochou. Je to jinej svět. Kytky se hejbaj a lidi kvetou. Sem tam nějaká kytka projde dveřma do jinýho prostoru. Pak to vypadá, že je kouzelná. Však je to taky kouzelná iluze, která je způsobena neskutečnou hrou pocitů, barev a hustejch nápadů. Není to k smíchu. Možná, že je to obraz něčeho, co nelze prohlásit ani za dobrý ani za špatný. Divokost, hrubost a děsná magořina.
Pohyb. Zvedá se a vytrhává kořeny z hlíny. Jde to snadno, protože zem je měkká. Překvapen zjišťuje, že může projít za zrcadlo. Opravdu je tam jiný svět. Něco co se vymyká normálnímu rozumu. Není to sen, není to halucinace, je to pouze realita. O nic víc jiná, než jakákoliv realita, kterou si můžete představit. Akorát má pocity vyhnaný do extrémů, žádnej střed, žádnej šit. Pořádný poctivý hustý pocity. Třeba na zvraceni. Je zábavnej.
Stromy. Každej stromá má svůj kořen. To je známá neodiskutovatelná věc. Strom můžete vykořenit. Je to zločin, a ten je třeba potrestat. Smrtí. Možná, že nikoliv, ale trestat je zapotřebí. Není trestu, není stromu. Stromy netřeba trestat. Stromy za nic nemůžou.
Dus. Dus. Dus. Vlak. O koleje duní ocelová kola. Dus dus dus. Lidé spí. Možná by stálo za to je vzbudit. Ale proč? Stejně sou ňáký hrozně divný. Žena se na něco ptá. Celkem nic důležitého. Nejspíš. Je jí špatně rozumět. Odpovědi se dočká v podobě zvířecího výkřiku. Prchá.
Píp. Píp. Otevřel oči. Nad hlavou měl přístroj. Pípal. Na obrazovce běžely tři čáry. Žlutá, zelená a modrá. Dvě rovný a jedna mírně vychylovaná. Nejspíš smrtí. Připadalo mu jako hloupost být živý. Smrt mu vychylovala jeho synchronizační cívky života. Život je svině, a smrt ještě větší. Problesklo někde mezi několika neurony. Malý, ale podstatný záblesk, který zapálil doutnák chuti. Radosti. A možná i štěstí.
Tik. Tak. Tak tak. Říkaly hodiny. Tak tak, utíká čas. Pořád stejně. Vteřinu za vteřinou. Minutu za minutou. Hodinu za hodinou. Den za dnem. Rok za rokem. Život za životem. Lidské životy se pořád střídají. Nejdřív jeden, pak druhý. Když zemře, vrátí se jako jiný. A možná taky ne. To záleží na tom, jestli se může vědomí samo od sebe, z vlastního rozhodnutí, přenést do nově vnikajícío života. Možná, že jo. Asi musí být ve velmi vhodné konstelaci. Jak moc je možno se vcítit do vědomí druhého? A jak moc je reálný vcítit se do bezvědomí? Jen malá modrá linka, která se občas rozkmitá pod záchvěvy napětí. Velmi vysokého.
Bez bolesti. Říká se, že myšlení nebolí. A bolí. Moc. Všechny ty elektrický signály, který probíhaj mezi jednotlivejma synapsema. Každej ten elektrickej výboj dá ránu. Jako když si šáhnete na elektrickej drát, kterej je nataženej okolo pastviny pro krávy. Nebo pro voly. To už je jedno. Aby ty svině neutekly. Takže, když každý krávě (nebo volovi či bejkovi) zavedete to mozku drát, víc drátů. Jeden k centrálnímu ovládání a ostatní k jednotlivým součástem společenství, budete je mít všechny pod kontrolou. Pošlete signál jednomu jedinému jedinci, ten jej přijme a po ostatních drátech pošle zbytku stáda. To se pak splaší a na vás bude, abyste je pomocí elektrickejch šoků dostali zpět pod kontrolu. Nebude to snadný, protože operátor musí být velmi rychlý a zkušený. By se mohlo stát, že se uklikne a jeden člen společenstva se odtrhne a poběží opačným směrem. Skoro jako Borgové. Hmm. Takže už na to někdo myslel. Borgové sou ve skutečnosti krávy. A bejci.
Zmrdi. Ne voni, já sem zmrd. Ne větší než Santa Klaus. Santu Klause mrdá civilizovanej svět. Santa Klaus je naklonovanej Hitler. Až na tu patku. Zdá se, že nějakým záhadným způsobem se jeho patka přetransformovala do hysterického plnovousu, kterým straší malé nebohé děti. Mohl by si s Dědou Mrázem podat ruce. Asi si však podali něco jiného. Je tu přeci Ježíšek. To je malej zmrd pro další generace. Až starý zmrdi umřou. Prostě rozmrdaná generace.
Prohlášení jedince z rozmrdaný generace: "Není to nic jiného než rozmrdanej život, rozmrdaný generace, rozmrdanýho světa. Jakej svět, takový lidi."
Na ja hjumaníci. Taxem se vyzvrátil nazpět do reality.
Nevím jak a kdo s říká co chce, ale nejpíš oceníte při svém veškerém smažení tento webovej odkaz, kterej Vám připomene, že byste neměli zapomenout vzít si pilulku.
A doufám, že ste se pořádně zasmáli. Protože tak zábavnej text sem už dlouho nenapsal... A to bych moh, moji milí mladí (a staří - na ty zatím seru), panáčci, ještě chvíli pokračovat. :-)
Aniž by ste tak chtěli, já budu. Po probuzení začíná novej den. Pokud se neprobudíte v noci. Pak začíná nová noc. V noci je to lepší než ve dne. V noci většina lidí spí a tak neruší ty ostatní svými myšlenkami. Noc ja taková čistější a jednoduší. Můžete se vcítit do lidí mnohem snáz, protože vlny s city nejsou rušeny balastem všedního. Můžete se vcítit, můžete vidět jejich očima, můžete potkat někoho zajmavýho. Na to nejní nic tristního. Horší to je, když se rozední a vy chcete vnímat svět jen pomocí pocitů a emocí. Jste tlačeni do vnímání všemi smysli, protože tak to po vás chtěj. A proč prostě nestačí, jen se vcítit. Proč je potřeba mluvit. Přeci stačí nevydat ani hlásku, pouhým pohledem řeknete víc. Čím širší zorničky, tím víc je do vás vidět. Stačí se jen zaměřit laserem a jste připojeni k očnímu nervu. Datový I/O. Smysly sou defakto naprosto k ničemu. Při troše snahy a pokročilejší technologii se lze zbavit tělesné schránky. Tato omezuje. Mozek je důležitý. Největší vynález biotechnologie. Bude ještě dlouho trvat, než evoluce zařídí zdegenerování těla do takové míry, že bude pouhou schránkou na mozek. S přírodním kompatibilním výstupem pro připojení ke globální síti individují, které si budou, bůhvíproč, říkat lidé. Mozek se bude nazývat člověkem.
13:08 - Díky velmi kvalitně nekvalitním službám narkomanského spolku, nazývajícího se zcela nelogicky d2.cz, opět nemůžu apdejtowat. Ještě, že za tenhle shitowej matroš nic nechtěj.... :-|
Je však otázka, jestli se opravdu vyplatí být připojen do globálního spojení, protože to je psyché. A nebo se rozum a inteligence přesunula do jiného rozměru???
>>>>>>>>>>>>>>>>>>>>>>>>>>>>>>>>>>>>>>>>>
entering hub CZECHKANAL 1
<<<<<<<<<<<<<<<<<<<<<<<<<<<<<<<<<<<<<<<<<
Hub-Security> This hub is running version 1.0.25 of the NeoModus Direct Connect Hub Software.
>>>>>>>>>>>>>>>>>>>>>>>>>>>>>>>>>>>>>>>>>
entering hub CZECHKANAL 1
<<<<<<<<<<<<<<<<<<<<<<<<<<<<<<<<<<<<<<<<<
>>>>>>>>>>>>>>>>>>>>>>>>>>>>>>>>>>>>>>>>>
entering hub CZECHKANAL 3
<<<<<<<<<<<<<<<<<<<<<<<<<<<<<<<<<<<<<<<<<
Hub-Security> This hub is running version 1.0.25 of the NeoModus Direct Connect Hub Software.
>>>>>>>>>>>>>>>>>>>>>>>>>>>>>>>>>>>>>>>>>
entering hub CZECHKANAL 3
<<<<<<<<<<<<<<<<<<<<<<<<<<<<<<<<<<<<<<<<<
>>>>>>>>>>>>>>>>>>>>>>>>>>>>>>>>>>>>>>>>>
entering hub CZECHKANAL 3
<<<<<<<<<<<<<<<<<<<<<<<<<<<<<<<<<<<<<<<<<
>>>>>>>>>>>>>>>>>>>>>>>>>>>>>>>>>>>>>>>>>
entering hub CZECHKANAL 1
<<<<<<<<<<<<<<<<<<<<<<<<<<<<<<<<<<<<<<<<<
lucaz> drus ?? tak promin
Drus> :))) naopak ... diky :)
lucaz> ta hlaska jdi na sever je super
Drus> tahle svenska ?
DRUSSwithAXE> Back to north, czech language here !
Drus> :)
plavacek> hele, drusik
plavacek> mam prosbu
plavacek> pridej do tech hlasek
plavacek> slovicko please
Drus> Hmmm, pravda ...
STOUPA> DOTAZ ... NEMATE nekdo program na ukladani aktualni obrazovky ???? ve WIN
plavacek> at vypadame jako slusny narod :)
STOUPA> DO JPG ....
crack111> STOUPA PrintScreen
lucaz> its true
crack111> :)
STOUPA> win 98 se ... printscreen ???
STOUPA> asi ne
jogobella> stoupa PRTSCR
Jaco007> Na slunečnici bylo něco a uklada to i vyrez, ale vse v BMP.
crack111> ale ano...
Drus> done
lucaz> PrtSc
STOUPA> a kam se to uklada ????
plavacek> do schranky
Drus> pleas ... takhle nejak Plavacku ? ;)
STOUPA> dikees
Drus> please
DRUSSwithAXE> Please ? Please ?? Is'nt a magic word here !!!
truly> a pak to vlipnes treba do corelphotopaint
jogobella> prtscr> schranka > phtshp
>>>>>>>>>>>>>>>>>>>>>>>>>>>>>>>>>>>>>>>>
entering hub CZECHKANAL 3
<<<<<<<<<<<<<<<<<<<<<<<<<<<<<<<<<<<<<<<<<
>>>>>>>>>>>>>>>>>>>>>>>>>>>>>>>>>>>>>>>>>
entering hub CZECHKANAL 1
<<<<<<<<<<<<<<<<<<<<<<<<<<<<<<<<<<<<<<<<<
crack111> :)))))))))))))))))
>>>>>>>>>>>>>>>>>>>>>>>>>>>>>>>>>>>>>>>>>
entering hub CZECHKANAL 3
<<<<<<<<<<<<<<<<<<<<<<<<<<<<<<<<<<<<<<<<<
>>>>>>>>>>>>>>>>>>>>>>>>>>>>>>>>>>>>>>>>>
entering hub CZECHKANAL 1
<<<<<<<<<<<<<<<<<<<<<<<<<<<<<<<<<<<<<<<<<
STOUPA> ja mam jen fixky, de to taky ????
jogobella> zjistit se da vsechno :)
parasite> hmm, to je ale v pr...
fruhba> proc nekdo neco nasdili, a pak to nedovoli stahnout ??? to nechapu
Sahlepik> quaka2??? :))))) prave sem ho doinstaloval,ale je to rar soubor
TAPU> a je to cd verze nebo osekana?
jogobella> to fakt netusim frughba
fruhba> pozdravuji uzivatel jmenem FLASH !!!! fakt inteligentni clovek
lucaz> ?? why?
Sahlepik> to nevim
Sahlepik> asi ta osekana,ale lne funkcni
STOUPA> jinak by se sem nedostal ....
Sahlepik> stoupitko,ahojky
truly> ted tu tak sedim a premejslim
STOUPA> kilnit te nemusi on ....
truly> je li jogobella zivej jogurt
Grogy> nad cim
fruhba> :))))) delas si srandu
STOUPA> muzes to met nastaveny blbe ty ....
fruhba> sam mi to napsal
STOUPA> ja se k nekomu taky nedostanu a to su A
lucaz> me to taky obcas dela dokola close
Grogy> je to urcite jednou jsem ji mel a ty byla tak ziva az mi utekla i na triko
STOUPA> tak ma plno
jogobella> jogurt s nozickama :)
fruhba> schvalne me vyhazuje !!
STOUPA> ja k sobe vic nez 8 lidi taky nepustim ....
Sahlepik> anthraxbella s miliony pratelskych bakterii
STOUPA> tak se na nej vyprdni a stahni jinde
Sahlepik> stoupiku,ale me kosem nedas.... 8-)
STOUPA> ne , tobe kladivem ....
fruhba> jenze to nikde neni.......hledam kabat > SUMA SUMARUM
TRACHTA> Prodam auto, strelim dum, a koupim si za to RUM !
jogobella> zenu ani krumpacem neuhodis..
TRACHTA> Prodam auto, strelim dum, a koupim si za to RUM !
Mori> ja to mam
plavacek> neboj fruhba
STOUPA> nma to se vyser, to je vyber ....
plavacek> uz na tom pracujeme
STOUPA> zitra to tu budou mit fseci ....
Kuchr> mori, uz sem tu a zapl sem ti ftp...
Mori> ok dik kuchr
Kuchr> ahoj generale plavacku
truly> ahooooj kuchriku
plavacek> nazdarek
Kuchr> trulyyy... ptala se po tobe sestra Helgy...
Grogy> cus kuchr
plavacek> jak bylo na exkurzi
plavacek> v JZD?
Sahlepik> Stoupiku,no tohle?! :)
Kuchr> cely vikend vyzvidala a ptala se a ... porad jen o tobe mluvila
fruhba> tak to asi jeste vydrzim do vecera, snad se to najde nekde jinde
Kuchr> v JZD to bylo o nicem, su silene nachlazenej a snad i nemocnej
Kuchr> do skoly jsem dneska ani nesel, jak je mi blbe.... prace venku mi moc dobre neudelala
jogobella> v JZD to silene smrdi
lucaz> coze nemoc sileneho kuchra?
p_a_l_o> lidi, nemate nekdo nebo nevite o nekom, kdo ma Office Developer ?
Kuchr> ty taky smrdis.... krava voni
Kuchr> palo..ja ne
p_a_l_o> nutne to potrebuju
jogobella> krava je posvatne zvire ty ses ale IND :)
p_a_l_o> stoji to pres 500
p_a_l_o> "Krava je tvuj bratr"
truly> co to je JZD?
Kuchr> takova jogobella nechana v lednicce o par tydnu dyl..to je aspon hnus.. zeleny, smradlavy a hnije to..takovej dobytek..ten nehnije
jogobella> he he IZER co?
p_a_l_o> :)
jogobella> kuchr dobre - umlatil si me argumentama :)))))
p_a_l_o> Office XP/2000 Developer
Kuchr> truly... to je jedno... je to jen takovy jako ja nevim.. brutus
Sahlepik> uffff
jogobella> dobytek je zas silenej - uz si videl nekdy nekde aby zesilel jogurt?
STOUPA> pro tvou informaci..... lydie je paseee
TAPU> nemoh by mi nekdo nasdilet cd verzi STRONGHOLDU?
Sahlepik> lidye je prase?! 8-)
Kuchr> jak se divam na tebe, tak muzu otevrene rict, ze sem videls silenej jogurt
Sahlepik> jo paseeeee :))) ja to spatne precet
Sahlepik> a co ted frci?!
jogobella> kuchr - ty vlastnis kamerku po drate? nooooo teda ty se mas?
Martin_Work> ma nekdo incubus plllsss?
>>>>>>>>>>>>>>>>>>>>>>>>>>>>>>>>>>>>>>>>>
entering hub CZECHKANAL 3
<<<<<<<<<<<<<<<<<<<<<<<<<<<<<<<<<<<<<<<<<
>>>>>>>>>>>>>>>>>>>>>>>>>>>>>>>>>>>>>>>>>
entering hub CZECHKANAL 3
<<<<<<<<<<<<<<<<<<<<<<<<<<<<<<<<<<<<<<<<<
Hub-Security> This hub is running version 1.0.25 of the NeoModus Direct Connect Hub Software.
Parazith> shanim empire earth. Nemate nekdo?
Colombo> Mrkni prosim jestli tam neni MAREK99 nebo podobny jmeno. DIK
>>>>>>>>>>>>>>>>>>>>>>>>>>>>>>>>>>>>>>>>>
entering hub CZECHKANAL 1
<<<<<<<<<<<<<<<<<<<<<<<<<<<<<<<<<<<<<<<<<
Kulhos> mejte se super, jdu domu... po 29 hodinach probdenych i DC
Kuchr> kulhos..mej se kocoure
sao> help, nutne potrebuji ser. cislo na Paint Shop Pro 7 , at hledam jak hledam, nemohu najit. Pomozte mi.
truly> ahoooj kulhoooos
Martin_Work> kulhos cuus
Martin_Work> stoupa diik
| 05.12.2001 |
10:40 - huztej slizkej předefčír za měsíc :)) |
Mejla s tímhle zněním jsem dostal wod Gibona. Nejdřív sem mu chtěl poslat mejla, ať už tyhle finty s hoaxama na moji maličkost nezkouší, jenže mi pak došlo, že Gibon je smažka největší a že v tom bude ňáká finta. Taxem si to přečet až do konce.. :)))
Warning!!! - Pozor!!!
V Internetu se začíná šířit zatím nejnebezpečnější virus!
Do počítače proniká protokolem ICMP a DNS dotazy, takže je prakticky
nezjistitelný a firewally jej nezadrží. Pokud dostanete e-mail se
slovem Badtimes v subjectu, okamžitě ho smažte bez čtení. Jde o
doposud vůbec ten nejnebezpečnější virus!!!
Po průniku do počítače nejprve rozbliká obrazovku na takovém
kmitočtu, že kdo se na ní podívá, je do dvou až tří sekund
zhypnotizován a upadne na své židli do alfa-spánku.
Poté virus roztočí pevný disk na tak vysoké obrátky, že plotny
disku prorazí kryt disku i počítače a uříznou spícímu
uživateli hlavu a jiné údy. Při tom dojde samozřejmě také ke ztrátě
všech dat z disku.
Nejen to, on zničí i všechny diskety položené poblíž počítače.
Přenastaví váš termostat v ledničce, takže vám roztaje zmrzlina a
srazí se vám mléko.
Demagnetizuje vám proužky na platebních kartách, zruší předvolby na
videu a pomocí prostorového harmonického pole poškrábe všechna CD,
která si budete chtít přehrát.
Vaší dívce změní telefonní číslo.
Do akvária vám naleje fridex.
Před příchodem návštěvy vám vypije všechno pivo a na stole nechá
špinavé fusekle.
Pošle tchyni pozvání na týdenní návštěvu.
Až zaspíte, schová vám klíče od auta a přeprogramuje vám autorádio
tak, že v zácpě uslyšíte jenom šum.
Vinou Badtime se zamilujete do zatvrzelého pedofila.
V noci se vám bude zdát o cirkusových trpajzlících.
Až vám vaše dívka zahne v hotelu, účet se připíše do vyúčtování
vaší Visa karty.
Badtime vám svede babičku, bez ohledu na to, jestli je mrtvá.
Taková je síla Badtime, že sahá až za hrob, aby se dotkl toho, co je nám
nejdražší.
Onemocníte tou nemocí, která napadá kaštany. Je zákeřná a vynalézavá.
Je nebezpečná a strašná.
A to jsem se zmínil jen o části toho, co umí!
Obavy jsou velmi, velmi na místě.
Horší virus neexistuje!
Okamžitě po obdržení tohoto dopisu jej rozešlete na všechny adresy,
které znáte; na každou z nich sedmkrát až třiadvacetkrát, protože
virus číhá na routerech a tyto dopisy žere. Ihned po rozeslání
vytrhněte počítač ze sítě a ze zásuvky a co nejrychleji utíkejte na
nejbližší kopec, kde vyčkejte na další informace.
.......Prominte, ale vzhledem k posledni sprsce HOAXu jsem si nemohl
odpustit poslat tento e-mail.
No, předpokládám, že odborník se zasměje, běžný user si řekne, že jemu se to stát nemůže a odklikne v outlůku novýho mejla...
Doufám, že se našel ňákej šílenec, kterej si řek, že můj včerejší zápis byl ňákej divnej. No a nebyl??? Zaručeně ne, protože co je normální a co je divný? Že jo? :-)) Každopádně je mi líp. A to o dost. :-))
Mno, v sobotu sem se potkal s Majklem (nazdarec xixte! :)) Pokud se dobře pomatuju, něco sme hulili. A bylo to hustý jaxvině, protože když sme se opustili, taxem šel s xixtama ještě na večeři, a tam to bylo sakra divný. Číšnice na nás mluvila fuckt ňákou hodně divnou řečí (skoro bych řek, že něco hodně vzdáleně podobnýho češtině), taxem si dal ňáký vegetarijánský rizoto. Dobrý, ale mastný. Jako cenově. Po jídle sme zase vyrazili někam na špeky.
Myslím, že fčera měla svátek svatá Bramborka. To je moc krásnej lidovej svátek. Musíte jít do sklepa najít nějakou bramboru, která ještě nestihla naklíčit. Což znamená, že je ještě k jídlu. Vezmete ji (v případě, že je to vaše poslední brambora vhodná k jídlu, tak to zkuste u sousedů) a přeneste do obývacího pokoje. Zde bramboru řádně omyjete, vyškubnete z qětináče fíkus a bramboru zasaďte. Ideální hloubka je kolem 8 cm a 6 milimetrů. A poté každý den, přesně v 18:46 musíte qětináč zalít. Když na štědrý den brambora vyqete, znamená to, že nesplesnivěla.
Tak taková je síla lidových zvyků. Sice si vědci nejsou přesně jisti co má tento zvyk přesně znamenat, ale podle několika indicií se jedná o spojení několika předkřesťanských kultů plodnosti a chutné stravy. Vyqetlá brambora nejspíš dokazovala matce kmene, že její plodnost bude pokračovat v příštím roce a že letošní zásoby jsou, prozatím, v nejlepším stavu (nebo ty sousedovic).
A možná, že se bude dít něco po obědě....
15:47 - Na ja, stavoval se u mě kamosch, jen tak na kus řeči a pro cédéčko s muzikou. Sem si naň konečně vzpomněl a udělal mu cédeso s Einsturzende Neubauten a The Extasy of St. Theresa. Po dvou měsících. Takže sem mu taky ukazoval deníček a von mi tvrdil, že sem mu nedal odkaz (což je dost nepravděpodobný, ale budiž). Samozřejmě, že sem se také pochlubil věrnými čtenáři. Teďka sem je xtěl vyjmenovat, ale na to seru, páčto bych mox někoho zapomenout, což byx nerad. Takže každej kdo si myslí, že je mi věrný, tak ať se PJEKNĚ HLASITĚ pozdraví. :))
No a paxme si povídali. Jako, že už sou z nás skoro důxodci, jaký je to deprimující, že esli by možná nebylo lepší přejít na drogy nebo aspoň někam, kde budeme dostávat hafo peněz za žádnou práci. Prostě bych se chtěl až do smrti flákat a přitom se mít dobře... :-))
| 06.12.2001 |
08:04 - dýler vždycky zvoní jednou krátce a dvakrát dlouze. A na rozdíl od pošťáka mi vždycky přinese psaníčko |
Kurwa, nejde nám Internet. Což pjekně nasere. Nemám přístup do sítě, takže jsem odříznut od ostatních členů společenstva. sic!
Nejspíš ňákej posranej problém s routováním, podle hlášek co mi lezou jako odezvy vod všech těch užitečnejch programů, který sou bez sítě zcela ouplně na howno. Ještě klika, že se mi včera podařilo konečně stáhnout ty Maléry pana účetního. :-)) Aspoň bude dneska na co koukat, když už nejde net.
Dozajista byl fčera svátek svatýho Mikulhashe. Páčto sem po městě potkal skupinky hax()rskejch CzERToo, 4Nd3100 a M1kU1h45h00. Ani bych se nedivili, kdyby se mezi nima objevil ňákej lamer. Napadá mě jen jeden, ale nebudu ho menovat, protože pomsta tučňáků císařských bude sladká.
Jo, a když už sem teda u toho. Jaxem tak šel po tej ulici, najednou BU BU BU BU, odněkaď vyběhla banda výše zmiňovaných šašků a přepadla skupinku jakýchsi nebohých děti, jenž šli přede mnou. Táxem si představil, jaká by byla prdel, kdybych na ně vyběh, zmlátil čerta s mikulhashem (popřípadně navíc znásilnil anděla) a wobral je wo wšechny ty dárky. Jo, asi by se panáčci dost divili. :)) A ten nápad mi připad tak legrační, že sem se musel zasmát (přičemž mi hlasitě uniklo HA HA). Ouplně právě v týhle chvíli mě napadlo, že kdybych byl pedofil, tak bych měl na Mikulhashe žně.
No jo, ale wona to nejní až tak bláznivá teorie. Co když byl původně Mikuláš vymyšlenej, aby si pedofilní církevní hodnostáři mohli legálně dosytosti užít aspoň jednou za rok. Přičemž se k nim časem přidávali další skupinky lidí. No a to odnášení dětí v pytlích?? To je hloupá pohádka pro rodiče, aby nemohli děti bránit. Protože, kterej rodič by půjčil dobrovolně svý dítě nějakýmu pedofilovi, kterej ho chce vošukat, že jo??? Takže rodiče sou klidný, protože si myslej, že jejich potomek je zcela v bezpečí, protože ho má v pytli jejich soused z baráku, kterej je takowej slušnej. Přičemž jim nepřipadá divný, že je furt svobodnej, mluví vysokým hláskem a pořád stojí před školou a rozdává bombónky. Prostě milý dítě je unešeno v černým pytli, pak někde vysypáno a zcela brutálně znásilněno nějakým debilem oblečeným do černejch chlupů, s rohama na hlavě a vocasem jaxvině. To se pak není co divit, že děti řvou, když viděl takový xixty v týfce, na ulici, nebo dokonce, když se do masky souká obtloustlý tatík.
Když už sem byl u těch dárků, co rozdávaj. Večer sem přišel domů a zjistil sem, že nemám nic k jídlu. Táxem si čet, pořád sem si čet, přičemž přicházel čím dál větší hlad. Tož sem sešel do kuchyně, ukrojil dva krajíce chleba a ty sem žvejkal. Je to pjekně hnusný jídlo, suchej chleba a k tomu voda. Taxem si stále čet. Pustil sem si týfku a koukal na poklad anešky český. To byla provokace. Celej tenhle díl byl vo jídle. Pořád mluvili vo kžepelkách na ruskej způsob, vo polívkách alá kabernet, ústřicích a ták. To už sem si říkal, že je to provokace jaxvině, taxem si šel smotnout špeka. Jako, že by to mohlo pomoct (samozřejmě, že sem věděl, že pak přijde ještě větší žravá). Sem si udělal takovýho malýho, půlku viržínka, zkouřil ho a šel si zase lehnout a číst si. Aneška česká skončila a blik... reklama... jídlo.... provokace... svině zasraný... blik... konec reklamy.. Se rozeběh pořad vo ňákejch nesmyslnejch úmrtích, kterej byl vo xixtovi, kerej si říkal Petr Novák nebo tak ňák podobně. Což mě dorazilo jaxvině, protože to už musela bejt ze strany český televize záměrná provokace, jelikož celej těch padesát minut žvanili vo tom, jak mu nechutnalo jíst, že byl zvyklej na kakawíčko vod babičky, a že jed akorát pivo, takže byl pořád hubenější a hubenější až nakonec umřel. Prostě provokace mé maličkosti. Jenže sem byl naštěstí tak silnej, že jsem odolal chuti týfku rozmlátit (stejně už skoro nefunguje), a šel si lehnout.
8:49 - Internet stále nejde. Zdá se, že to bude vážný. A je mi jasný, jak na to tady každej sere, že se ním nikdo zabejvat nebude. :(
Jo, holt, jedinej důsledek celýho tohodle maléru, řekl bych skoro průseru, je ten, že toho dneska napíšu zasraně hodně. Už to vidím, jak mi BAF pošle mesydž, že je to strašně dlouhý, že to odmítá číst. Že musí pracovat a dodělat ten web pro bin Ládýna. Prej to dá hroznou práci nasrat do databáze přehled všech továren na výrobu antraxu, co mi tvrdil posledně, je toho aspoň na tejden. Co továrna, to jiná značka Antraxu. Jiná xuť, jiná qalita. Podstatná je ta dlouhotrvající chuť, která vám zůstane na jazyku, i když ste už dvanáct hodin mrtvý.. :-)
Docela se mi líbí, jaxxe říká "Zařvalo tam aspoň patnáct lidí." To je taky docela zcestný. Si představte, že ste někde v epicentru například jadernýho výbuchu. Si nejsem vůbec jistej tím, že stihnete zařvat. Myslím, že první co uvidíte bude jasnej záblesk a poslední co váš mozek stihne zpracovat bude dlouhej tunel s bílým světlem na konci. I když to musí bejt prdel, například až Amerikáni zase v Afgánistánu použijou svůj oblíbenej napalm. Možná, že už ho použili. Třeba se pokusej z Tora Bora vyplavit bin Ladina napalmem. Skoro jako fašouni, když liqidovali paragány, který sejmuli magora říškýho grupen něco Hajdrycha. (a hele asi sem vymyslel ftip. napsal sem totiž, že je fašouni liqidovali a možná, že někdo ví, že se je náckové pokusili vyplavit vodou z tý jejich kobky. Prostě jedno slovo označí celej ten průser. Místo, aby dneska musela bejt na zdi velká mramorová deska s nápis "Zde byli brutálně vyplaveni vodou hrdinní bojovníci proti fašismu. atd...", postačí měděná destička s textem "Zde byli zliqidováni: no a ňáký jména". Akorát se bojim toho, že by někdo tu měděnou desku stejně ukrad.)
Zrowna sem napsal docela hustej odstavec, ale paxem ho smazal, protože mě to přestalo bavit. Sem se chtěl pokusit o povídku, ale není tady na to ta správná atmosféra. A hlavně. Psát bez nápadu je pjekná kravina.
9:21 - Tak stále Internet nejde. Asi pudu dneska brzo domů. Typnul bych si, že by možná nakonec stačilo restartnou ty posraný Orinoka. Určitě se jim stalo něco takovýho hnusnýho, za co si zasloužej bejt restartnutý.
KURWA! Sem si teďka vzpomněl, když sem mluvil wo tom restartu, co mě fčera ale MEGANASRALO. Bill Gates. Ten hnusnej tlustej hajzlík přijel do Prahy. A ňákej televizní mamrd si dovolil tohodle billa gatese nazvat duchovním otcem internetu! Normálně se ve mě obrátili vnitřnosti naruby a já se málem poblil, když sem to slyšel. Prej duchovní otec... HA HA HA... ještě teďka, když si vzpomenu, že mrchosoft dohnal svoje spoždění v dobývání internetu jen díky tomu, že se mohli ten svůj browser integrovat do systému. Brr... Nakonec ho pozvali do nějaký posraný školy, kde házel kydy na chudáky malý děti, jako že nejní namyšlenej, když nemá prachy, že se aspoň může věnovat rodině a tág.. btw. von má rodinu??????
Už na to seru. Je 10:09 a konečně nám de Internet!!!
13:20 - Vlastně sem si ještě vzpomněl na jednu záhadnou věc. Fotbal. Jo, myslím tu hru. Nemám nic proti tej hře. Rozumím jí velice dobře. Hlavně, když sedíme v hospodě, dokážu si o ní povídat jako nejzapálenější fanoušek. Znám takový výrazy jako "fuck off side", "rozhočí je píča" či "HU HU". Rozumím i systému na kterém jsou založeny principy této velice hezké hry. 2x11 týpků v barevných tričkách pobíhají po ploše o rozloze fotbalovýho hřiště a honěj takovou měkkou kouli. To fšechno mi je jasný, ale za boha nechápu jednu věc. Proč se fotbal hraje v zimě. Vždycky sem měl za to, že fotbal je letní hra a hokej zimní. Ale když sem fčera koukal na týfku a zjistil, že dávaj přenos s fotbalovýho utkání, taxem koukal jako blázen. Venku aspoň mínus 123 minut, maníci v trenkách, tričkách a rukavicích. Fakt sem to nějak nepobral. A to sem se ptal kamarádů (například Tyqičky - a ten tomu musí rozumět, protože hraje ňákou D třídu u nás na venkově), proč se jako fotbal hraje v zimě a né v létě???? Najde se někdo, kdo mi tuhle záhadu osvětlí????
15:11 - Mi to nedá, ale objevil sem luksusní sajtu: http://www.scienceworld.cz.
| 07.12.2001 |
09:49 - Copak je to za čůráka? |
Jo, tak tuhle hlášku co sem napsal sem vymyslel dneska ráno, když sem byl přinucen pracovat rukama. Sme tak ňák tahali prkna sem a tam a já si vzpomněl, že kdysi běžel ňákej film "Copak je to za vojáka?" A jako naprosto volná asociace mě napadlo, když sem se viděl jak tam tak běháme s těma prknama, "Copak je to za čůráka?". Prostě to vystihlo situaci.
Ale vo tom dneska psát ani tak nechci. Sem si řek, že bych se moch věnovat lidem a ptákům. Takže asi začnu těma ptákama...
Ptíci:
Si to takhle du z vlaku po ulici. A uviděl jsem hejno vran (no možná havranů). Tu mě napadlo: "Ty ptáci se maj. Si tak lítaj v tom hejnu sem a tam. Vobčas se ňákej splaší a hejno se vrhne za ním. Nejlepší však je, že jaxi tak lítaj, sou svobodný a serou na lidi...."
Jo, tohle mě napadlo. A pak ty lidi. Uvidíte, že lidi sou taky zajmavý, ale ti ptáci...
Osoba č.1.: Paní s extra hnusným kloboukem:
Čas wod času potkávám ráno osobu. Ne hnusnou, ale prostě na pohled tak zajmavou, že se vždycky zarazím. Je to jedna s těch žen (případné, čtenářky jistě teďka prominou, ale přeci jen píšu deník, a taxi tam můžu napsat co xci.. :)), kterejm osobně říkám "pečenáči". Tohle slovo vymyslel kdysi dávno můj bratr, když hrál gamesu Crusader - No Remorse, kde moch borec chodit s plamenometem a pjekně upalovat postavičky. Jak taková "pečenáč", jenž potkávám, vypadá? No fakt divně. Její pleť je vypálená umělým sluncem ze solária a pokrytá silnou vrstvou mejkapu, kterej zakrejvá veškeré drobnosti a nedokonalosti obličeje. (a trochu připomíná pečený kuře :)) Pleť vypadá jako pokrytá sametem, dokonale a naprosto bez chyb. Prostě dokonalá prácička vizážisty či vizážistky. Myslím, že je to docela nechutný, protože právě ty drobné nedokonalosti a nesrovnalosti dělaj člověka člověkem, jedinečným individuem. Tož dále, obvykle mívá na sobě nějakej kožich a kozačky. Jenže to nejní to podstatný. Ať si každej chodí jak xce, to je mi celkem u prdele (buď se líbí nebo se nelíbí, to je mi fuckt). Co mě fšak neskonale fascinuje je její klobouk. Jo, klobouk. Protože nikdy v životě sem neviděl nic tak hustýho. Jak vypadá? Fakt hustě.
Představte si kužel. Pokud nevíte, jak vypadá kužel, taxi představte jehlan. Ten má (nejspíš obvykle) štvercovou základnu, kužel má základnu kruhovou (kurwa, doufám, že nekecám :)) Představte si ten kužel, s šířkou kruhové základny rovnou zhruba dvojnásobku šířky hlavy. Teďka mu uřízněte špičku (a tu klidně zahoďte, nejni podstatná). Cirka tak, aby zůstal objekt, kterej má defakto dvě základny. Ta spodní je širší než ta seříznutá (zcela pochopitelně, že?? :)). Šiřka podstavy, kterou ste si uřízli, je zhruba stejná jako je šířka hlavy. No a v týhle podstavě si vydlabejte ňákej otvor a výsledek si posaďte na hlavu. Samozřejmě, že dotyčná paní, má celý tento produkt potažen ještě nějakou chlupatou kůží, ale to už je jen takowej drobnej detail. Prostě hustej klobouk.
Osoba č.2.: Krychlič:
Sem včera v Pardubkách potkal Krychliče. Esli neznáte Krychliče, tak to vo hodně přicházíte. Krychlič je totiž místní rarita. To je člověk, co kterým skoro nic nevím, kromě několika fám, co si ho pomatuju, tak pořád chodí v šedivým balóňáku, pod nosem elegantní knírek, v ruce aktovku, a na hlavě krychli. No jasně, krychli. Proto, krychlič.
Vlastně ani nevím z čeho ta krychle je vyrobená. Vypadá jako vydlabaná ze dřeva, jenže tahle varianta mi připadá dost zcestná. Prostě nevim. Sou lidi, který mi tvrděj, že sou to jeho pravý vlasy, ale že je má stužený Lybarem, někdo mi říká, že je to prej paruka aspoň třicet let stará. Ať je to co je to, Krychlič je právě zajmavej tím, že vo něm nic nevim. :)) Někdo říká, že je to bejvalej učitel, co měl rád děti víc než je zdrávo, někdo říká, že žije v harmonickým vztahu s přítelem, někdo mi zase tvrdí, že je to bejvalej kreslič z ňákýho stavebního podniku. Fakt nevim. Prostě je to fascinující figurka města Pardubic, stejně jako Franta Gott (či jaxe mu říká), kterýho ráno potkáte v černý nebo červený (jakoby policejní) kukle na hlavě, přes kterou má sluchátka a zpívá si třeba právě Zvonky šťastia...
Tak to je skoro všechno. Až na tenhle článek. Esli máte nějakým nešťastným zůsobem děti, taxi přečtěte tohle povídání: Is Your Son a Computer Hacker?. Kromě toho, že se mi o něm zmiňoval BAF, taxe teďka rozeběhla na konferenci linux.cz docela hustá debata, a já mám takowej pocit, že některý lidi prostě nepochopili, že je to celkem vypečenej ftípek.. :)))
11:31 - Něco pro muže. :-))
| 10.12.2001 |
14:32 - Týýý wolowé! Sněží tu jaxvině! |
Ty jo, normálně tu sněží. A hustě....
Dneska bude kydů pomálu, protože dnešní podstatný update je ve fotografiích. Táákže, pokud xcete vidět moji letošní ourodu a hafo jinejch fotek, VZHŮRU DO FOTOGALERIE! :-)) A řiťte se datumama... :)
Hmm. Takže co jinak podstanýho. Někdo mi volal a chtěl po mě vědět esli nevim, kde bydlí Honza Votrubec. Táxem řek, že newim. No co jináč? Možná, že za útok na dvojčata můžou mimogáči.
| 11.12.2001 |
12:37 - A nasněžilo. Tolik sněhu v jedný tašce... |
Sem se před malou chvílí díval na statistiky náfštěvnosti a až sem se normálně lek. Za včerejšek 105 náfštěv, z čehož bylo 70nových!! a 35 opakovaných. Sem si xvilku říkal, esli tou čistě nejní těma fotkama. :)))
Ty jo, viděl jsem úplně boží film. Ghost in Shell. Pokud máte rádi kyberpunk a hodně ulítlý filmy, vřele doporučuju. Po zhlídnutí zjistíte, že například takovej Matrix (a že se z něj dělá hustě kultovní film) je slabej jaxvině, a hlavně autoři Matrixu vykrádali. Jo, vykrádali z Ghost In shell. A to takovým způsobem, že sem si myslel, že spolíhali na to, že Ghost In Shell nikdo nikdy neuvidí. Pokud se chcete o tomhle megahustým filmu něco dozvědět, tak buď na http://underground.cz/clanek.html?id=374 a nebo http://www.kinofil.cz/eorecenze/30934. Jo, a věřte mi, že když v těch recenzích píšou, že se na to dá koukat podruhý i potřetí, je to pravda. Už sem to viděl dvakrát a bylo to wo dost lepší.... :-)))
Dělá mi radost sníh. Je to príma, dávat si večer špeka a koukat jak sněží. V případě, že máte do čeho ubalit. :)) Sem měl dneska ráno, když sem vyrazil do víru dění, že sníh je něco jako civilizační choroba. Takovej krásnej přírodní produkt, lidi by z něj měli mít radost a ne se snížit k něčemu tak malicherně zbytečnýmu jako je nadávání "už aby bylo léto, jen abysme mohli vlétě nadávat, že už aby byla zima." Mám jen holt pocit, že když dneska napadne sníh, musej vyjet ven čističi a jen qůli tomu, že automobilisti nemůžou na silnice to všechno vosolej a zliqidujou. Proboha proč? Proč se snažíme svázat přírodu jen kqůli našemu pohodlí. Moc se těším až dojdou zásoby ropy. Jo to se všichni ti zasraný automobilisti udou pjekně rozčilovat, že nejní benzín. Včera sem totiž čekal na přechodu a dost sem se vytočil. I chůze pěšího usera se řídí podle provozu. Mívám pocit, že chodec je něco jako parazit. Že je něco, co dokáže motoristům zbrzdit a sprznit jejich rychlý průjezd městem. Kurwa, já sem fčera asi pjet minut čekal na křižovatce na zelenou, protože ty posraný semafóry sou řízený počítačem podle hustoty provozu. A že chodců bylo málo a aut hodně (a v každým po jednom vocasu), taxem čekal zasraně dlouho. A to mě vytáčelo. Pořád se musím ptát, kdo je víc? Železná vobluda nebo já, jako člověk z masa a kostí. Nepočítaje v to aroganci některých řidičů.....
No jo no, newim co napsat. Sem si zakřičel. Ublížený miminko se mohlo vyválet v blátě, aniž by někomu ublížilo. A co teď a co dál????
Fakt newim co psat. Možná to, že sem dneska furt někam lítal, howno udělal a navíc se už ztmívá...
| 12.12.2001 |
11:09 - Sníh je největší nepřítel školníků na čtyři. |
Ouuu jééé. Tak je tu další den a s ním i výkřik do temnoty. Nejdřív si musím zareagovat na Kristiánuv vzkaz v náfštěvní knize. Jo, myslim, člověče, že to bude mega vychytaná pjestírna. Ani bych se nedivil, kdyby byla ve speciální izolovaný místnosti, kde jediný pojítko se světem sou těžký, 30cm tlustý, olověný dveře a děsně vychytaná klimatizace s filtrama fungujících na subatomární úrovni. Někde v rohu by ze zdi čouhal na ruku tlustej svazek optickejch vláken, kterej by končil ve velký černý krabičce, napájené přenosným jaderným reaktorem vzor MicroThemeleen 6., s nápisem Ganjamancer (zde si jistě sečtělý čtenář všimne trapné a velmi ubohé narážky na knížku Neuromancer od literárního boha - a tím nemyslím JXD!!! - W. Gibsona, zvláště pokud víte jakým způsobem vzniklo slovo Neuromancer.. :)) Předpokládám plnou automatizaci celé pěstírny, takže by nejspíš měla bejt schopná udržet a rozmožovat kytičky i v případě totální vyhlazovací atomové války a to aspoň po dobu deseti až patnácti let. Ganjamancer je umělá inteligence šesté generace, která již nemá jádro postavené na inteligenčním jádře firmy Microsoft. Proto se dokáže rozhodovat sama a svítí již podle harmonogramu a neblbne kytky modrým světlem. Komunikace s touto UI probíhá mimosmyslovým vnímáním, přes retranslační mikročip, který má majitel implantován přímo do hlavy. Jedinej problém, kterej se může vyskytnou je, že když má UI dobrou náladu, tak svého majitele může jen tak z legrace třeba dostávat do stavů velmi změněného vědomí, ve kterém se mu snaží vysvětlil, proč je dobrý, že ho k těm kytkám nechce pustit. :-))
Hezkýýý.... 13:12 - Koukám 3800 hitů. Sem si nikdy nepomyslel, že se takovýho čísla můžu dočkat. Je to moc fajn. :)) Sem si taky zkouknul statistiky, a si jako myslíte, že těma třema hlasama pro to, že santa klauz je prima chlapík, mě, vy svině, vytočíte??? Se pjekně e-mejlíte...
Ty jo, zrowna, když sem musel vyplňovat nějaký posraný papíry a výst diskuzi ohledně zkoušek, sem slyšel zapnutý rádijo, jak v něm vysluvojou slova "represe", "poslanec Pejřil" a "valná většina poslanců", ale co a jak, to sem bohužel neslyšel, protože moje snaha vysvětlil kolegům, že bych si rád poslech jak to s tou trávou dopadlo se minula účinkem. :(
A závěrem. Ste si jiště všimli, že začíná období devastace našich lesů pod jakousi pochybnou záminkou vánočních stromečků. Zde, ve městě, se rozmohla podivná móda věšení stromečků z oken vzhůru nohama. No jo, je to tak. Včera sem si toho všimnul poprvý, když sem s panem Ůčetním šel od nádraží, táxme koukali, jak pěkně z wokna jednoho činžáku visí, přivázán provazem, smrček. A taxem se díval pečlivěji a našel takowejch případů ve svém okolí více. Ano, čím více se budou lidi chovat jako magoři, tím lépe.
| 13.12.2001 |
10:19 - Slunce svítí, na nebi ani obláček a mráz jaxvině |
Kurwa, sem se ráno probudil. Oblík, opláx si xixt, nazul boty a otevřel dveře. Mrrrrrrrrzzzzzz. Sem se zastavil, a když mýmu tělu došlo, že je zima, roztřáslo se jaxvině. Zima, vopravdu hnusnej a hustej mráz. Jeden z těch zasranejch důxodců Mrázů, který pruděj mladý nebohý lidi, když dou poránu na vlak. Na nebi ani obláček, zadnej sníh a na východě slunce. Prostě klasickej příznak, že přes den bude pjekně drrrsnej holomráz. Takowej zasranej, co vleze i pod rukavice, pokud je máte, a když je nemáte, tak nemůžete hejbat prstama. A ještě aby se neřeklo, fučel vítr, přesně proti směru chůze. Takže všemi otvory v oděvu, mezi knoflíkama, zipem, prolez až na kůže a tam provokoval.
Takže všichni lidi, co čekali na nádru, měli takový pjekný, od mrazu, vyšlehaný obličeje, pjekně do červena. A hlavně se fšichni nasrali do čekárny, takže si nebylo kam stoupnout, natož sednout. :(
Ale to jistá cena za to, že někam dojíždíte. Má to zase svoje kouzlo, protože se potkáte se známejma, a můžete vtipnejma hláškama bavit své spolucestující (resp. spolustojící v chodbičce) ve vlaku ftipnejma hláškama jako třeba: "no to by byla prdel, kdybysme odmítli otevřít dveře, a všichni kteří by se pokoušeli dostat dovnitř zvenčí by dostali botou mezi woči." nebo "co kdybysme ty dveře otevřeli za jízdy". Prostě ve vlaku po ránu se dá zažít spousta legrace na úkor cestujících. :))
A vono se dá ve vlaku dobře experimentovat na lidech. Vcelku beztrestně a legálně. Například (asi sem ho už nejspíš popisowal, ale je to můj nejoblíbenější) kupáče. Musíte si vyhlídnout kupáč ve kterým nikdo nejní. Vleze doň a otevřete dveře a sednete si hnedka ke dveřím, protože u okna musí zůstat volno, aby si tam mohli lidi přisednout. Nejlepší je tento experiment propagovat na jaře nebo na podzim, kdy je celkem ještě teplo, pokud teda vlak stojí, ale zase ne takový, aby nevadil proud chladnějšího vzduchu proudící do kupé během jízdy. A v čem spočívá celej experiment??? Zjistil sem totiž (teda možná, že pro to existuje jiný vysvětlení, ale von něm já newim), že lidi neradi dělaj něco, s čím nemaj nic společnýho. Tákže, když si přisednou do experimentálního kupé a okno je otevřený, obvykle trvá dost dlouho než ho zavřou, jelikož si nejsou jistý (proč je otevřený - nejspíš teda). A někdy ho ani nezavřou vůbec. Stal jsem se svědkem, kdy se mnou jeli jakési dvě postarší ženy a ty si radši asi každejch patnáct minut střídaly místo k sezení, místo aby zavřeli wokno, Tákže, ač mi byla zima, výtečně sem se bavil tím, jaxe pjekně točej dokolečka, nejdřív jedna po směru jízdy a pak ta druhá. Fakt, nevim. Podle mne za to může lidská lhostejnost a nezájem o druhý, takže to samý můžete zažít, čekáte-li v čekárně a někdo nezavře dveře, to radši fšichni klepaj kosu, ale ty zasraný dveře zavřít nejdou. No, možná, že sou inteligentnější než já a říkaj si, že to nemá význam, že je stejně zase někdo nechá otevřený. Tak radši klepaj kosu....... Kruci, to sou ale blbý kecy, že jo??? :)))
Jo, podívejte se na co dneska BAF narazil. Jediný štěstí je, že jako hulič jsem tak tou marihánou zdegenerowanej, s absolutním nezájmem o okolní svět a skelným zrakem, že už sem neměl sílu reagovat.... A nebo naštěstí?????
Začínám mít hlad jaxvině. Sem se dneska dozvěděl, že zejtra bude many many. :-) Taxem zvědavej, esli nedostanu dlouhej nos.
13:39 - Můj milý deníčku. Venku je kurwa zasraná zima.
Tak, ještě se podívejte, jak jednoduše začal před deseti lety fungowat WWW.
14:44 - Dal sem si tu práci a přečetl si zápis ze čtení v PSP Pejřilova návrhu novely protidrogového zákona. Teda, je to dlouhý jaxvině, místy je to tak drssný čtení, zwláště, co dokáží někteří poslanci vyplodit, ale jedinej způsob je prostě ignorowat ignoranty, zůstat v podzemí a v pohodě... :-(((
| 14.12.2001 |
10:02 - Many many, aj laf many many... |
Móre many. Dostal sem prašulky, kulaťoučký zlaťáčky. Z papíru.
Taxem ráno potkal Rancida. Šel do práce a taxem si ním dal cigáro. Sme se tak bavili, jako že je pjekná kláda a že na teploměru bylo po ránu minus 12 stupňů. Takže kláda jaxvině. A pak mu jel autobass, táxem šel zase po svejch. Do ústavu.
Sem si taky vzal na vánoce dovolenou. Asi pojedu někam na vejlet. Možná na xatu k řece Sázavě. Možná, že se bude dít něco nepřirozeného a tak u toho budu chtít bejt. Třeba se něco bude dít s vesmírem. Kdo ví, je to dost nejistý.
Podle statistky mi na ethernetu proteklo od úterka 4068.95MB. Fcelku zajmavý číslo. Asi sem překonal rekord. Jó holt, když vás nafštěvujou lidi s noutbůkama, co s tím naděláte. :))
Nerad chodím o přestávce ven. Na chodbách je takowej zasranej provoz, až to rozčiluje. Lepší to je o hodinách. Nikdo nikde, potkáte sem tam akorát nějakou mrtvou duši. To je prima. Kurwa, mě to nějak dneska nebaví. Si na mě leze ňáká zasraná nemoc, taxem ňákej unavenej a ospalej. :(
13:34 - Houps, mi to nedá napsat o zábavný historce z oběda.
Sem šel na oběd, kde sem potkal našeho vrátnýho. Což je klasickej důxodce. Doktory má naplánovaný v kalendáři už na tři měsíce dopředu, má vychytaný všechny slevy ve městě (takže ví, kde sou levný šroubky a ták) a je mu asi šedesát. Vlastně nevim kolik mu je, ale v důxodu už je určitě. Tak tam tak s náma seděl, občas řekl něco zajmavýho, jako že je italský počasí a ták. Pak dojed, vstal, významě položil na stůl svoji novou čepici a odešel vrátit podnos s talířema a příborama. Taxem se tak podíval na tu čapku, taková ta moderní, znařková, co ji prodává Vietkong na tržištích. Co mě však zarazilo, byl vyšitej nápis zepředu čepice. Milej vrátnej tam totiž měl napsáno "Freak - Mad Boy". Taxme se s Jindřichem zasmáli, protože asi nejspíš vrátnej neví co to znamená, protože jinak by si čepici s hrdostí nenasazoval. :))))
| 17.12.2001 |
12:46 - Mám toho sněhu plný zuby a nos |
Oh je saddam underground. Na www.koukat.cz vyšel můj poslední týdeníček. A chtěl bych upozornit, že tento týdeníček byl zahax()rovanej samotným "#RedHackerem" a nebo "#RatHackerem"??? I když jsem se teďka stal obětí komplotu a jeden nejmenovaný DJ se mě po ICQ ptal, jestli to červený tam opravdu vložil ON osobně.
No, ale sou horší věci. Třeba děti v Africe.
No to me poser. Xce se mi srát, tak na to seru, jenže se to stalo teďka neúnosným, ba dokonce velmi neudržitelným, táxem se zved a šel se teda vysrat. Wotevřu dveře a wono je obsazýno. To mě nasralo....
Btw., Majkle, jak dopadly ty feferonky?? Dobrý???? :)))
Táxem se konečně vysral. Dostal jsem děsnou xuť na hašiš. Asi si o něm nechám zdát.
Jo, tohle mi přišlo poštou. Pravděpodobně prapočátek veškerého zla. :-)
Ty jo, teče mi z nosu, teče mi z vočí, málem i z uší. Hulení nepomáhá, kurwa co to je??? Asi ňáká moc.
| 18.12.2001 |
09:37 - The End Of Dark Psychedelia |
Ty wole, Majkle, to je hodně hustý řešení boje feferonkama proti holomrázu. Huž se vidím, jak každý ráno vstanu v půl sedmý z postele, udělám takowou tu hygienu, abych smrděl trochu víc, wotevřu ledničku, vyndám zavařovačku, sundám víčko, vytáhnu feferonku a vrazím si ji do huby. No a vzhledem k tomu, že to mám na nádraží pomalou chůzí asi deset minut, tak bych ji stihnul pořádně rozkousat, pak nějaký to stání ve frontě na lístek, a když bych přišel na řadu, tág byx votevřel hubu a řekl "Jeden lístek tam" a pořádně poprskal wýdejní vokýnko červenejma pálivejma slinama.
To by se asi ta tlustá, blbá ženská za wokýnkem divila. Dost možná, že ne. Protože ona je schopná čumět z wokna, i když je v čekárně fronta omotoná dvakrát dokola.
Dneska sem viděl totální zoufalství. Si to tak stojím na peróně a čekám na vlak. Nejdřív přijel rychlík z druhý strany, jedoucí opačným směren než sem měl namířeno já. Je to celkem důležitej spoj. A dneska, zcela nečekaně, přijel podle jízdního řádu. Což některý lidi zmátlo tak, že prostě nestíhali.
Najednou se rychlík rozjel, nebylo to náhodou - výpravčí to odmáf, a z čekárny se vyřítila ženská, cirka třicet bych řek, a vrhla se mezi koleje. Sem si říkal, kurwa co blbne, to chce jako dveře otevřít z druhý strany perónu, dyk je ten vlak rozjet. A vona asi jo, protože křičela něco ve smyslu jako, že spěchá, ať počkaj, jenže vlak už nabíral rychlost. Asi tak deset sekund tam stála, mezi těma kolejema a vyloženě na ní bylo vidět, jak svým tělem cuká, jak přemejšlí, esli to stojí za risk, zkusit otevřít dveře za jízdy a ještě naskočit (dyk v těch akčních filmech to vypadá tak snadně). Paxi to, k mýmu zklamaní, rozmyslela a vrátila se zpět. Cestou odchytla nějakýho zoufalce a tomu si postěžovala, že je to hrozný, že ty český dráhy stojej za howno a táák... To je vidět, že lidem se nikdy nezavděčíte, protože když maj vlaky sekeru, tak každej nadává, že sou český dráhy na píču a ještě ty svině xtěj v lednu zase zdražovat, a když vlak jede na sekundu přesně, taxe taky najde někdo, kdo musí nadávat, že je to na howno.
Kurwa, dneska sem se výtečně zasmál. (Sorráč, ale musel sem) Ukrad jsem ten obrázek z kompostu a vůbec mi to nejní líto, protože je hůůstej.

Hustý, co??
Mna, i amketa se začíná pjekně rýsovat. Zdá se, že v panuje představa, že Santa Klaus je odpornej důchodce. A jelikož je to názor většiny, tak na tom asi něco bude... :-))
10:25 - Táxem se byl vysrat. A vysral sem se do růžova, to mi věřte. Dočista....
Blbý je, že musím za prací....
12:33 - Oběd byl dobrej, ale newim proč, připadal sem si jak v důxoďáku, když sem žvejkal kus toho žwance.
Je to divný...
15:55 - Jdouce po ústavní chodbě, měl sem pocit, že cejtím chcíplou rybu. Fakt neskutečnej smrad.....
Hmmm... Tak co s Afganistánem. Hlavně, že už válka zkončila, nastal mír a spravedlnost se vyzwrátila do starých kolejí. S čímž souvisí německá pohádka o Kočičce.
Dostal jsem mejla od Kamily. Možná, že si někdo vzpomene, jaxem o ní psal (měl jsem sto chutí napsat "s láskou", ale von by to moch někdo blbě pochopit... :)) a o jejích stafilokokách. Tak přesně wod sem dostal mejla. Vždy, když mi něco přijde, děsně se pobavím a vylekám, páčto takový normální a vobyčejný mejly mi choděj naprosto minimálně. Teda skoro vůbec. A tohle sem wod ní dostal v rámci nějaké internetowé pohlednice:
Taky hustý, co?? Něco tak prima hnusnýho se jen tak nevidí.... :-))) Fakt by mě zajimalo, jakej chorej mozek to dokázal vymyslet.
Včera večer se u mne na ústavu stavoval BAF. Taxme si šli dát špeka a zhulili sme se. Jak jinak, že??? A celkem příjemně. Takříkajíc vánočně. Byl to přesně ten krásnej vánoční staf, kterej lidi obvykle nepoznaj. To si dete po silnici, chodníky narvaný lidma jaxe tlačej sem a tam, ste šťastný, že ste zhulený a ještě navíc v předvánočním shonu. Taková dvojnásobná radost z toho, že právě VY si ty vánoce užívate. Pohoda, klídek, sem tam se někam podívate, a hlavně to litování lidí co furt někam lítaj, slíděj a sháněj, a přes všechno to televizní vychvalování vánoční pohody, sou děsně v prdeli, protože hormony jim vyhodily stres na maksimální hranici, doma sou nervozní, protože děcka řvou, stromeček opádává v koutě, prádlo je potřeba vyprat, uklidit, rozeslat vánoční přání, napíct cukroví, ulovit kapra. Prostě všechny ty činnosti, který sloužej k tomu, aby se člověk dostal do parádně rozesraný nálady, i když vám na Nově prezentujou, že sou lidi vlastně šťastný. Což v současný atmosféře vypadá nepravděpodobně. Ale sou lidi, který sou o vánocích šťastný, kromě několika úchylů, jsou to i huliči, protože choděj zhulený po vánočním městě a sou šťastný, že prostě tyhle podělaný problémy nemaj, proto choděj, tleměj se na lidi, jako že je príma pohodička a lidi sou nasraný, protože nechápou vo co gou.
A pokud se vám do toho spustí i krev z nosu. To je nakonec nejlepší završení předvánočního shonu. Dete si, krásnej teplej pocit nejdřív v nose, pak pod nosem, nakonec na celý držce. Prostě pohodičkáááá. :-))
Paxem teda přijel domů, udělal ještě jednoho špeka a šel si postřílet pár xixtů. Jen tak, pro relaxaci... :))
Jo a na závěr. Zjišťuju, že se začíná objevovat novej výraz pro vyhledávání na internetu. Místo "vyhledal jsem něco" se použije "vygoogloval jsem něco".... :-)))
| 20.12.2001 |
10:43 - Sehr geehrter Kunde! |
Táxem chtěl dneska chcát slinty už od rána, jenže jaxi z toho sešlo. Musel jsem přemejšlet. Vcelku však příjemně. Potvrdila se má domněnka ohledně programu Direct Connect, kterej je něco jako Napster. Problém byl f tom, že některý kanály jsou nepřístupný, páčto chtěj abyste měli nazdílenejch třeba 50GB. No jak uznáte, tolik místa na disku má celkem málokdo a taxe tady řešila následující otázka. Nepůjde to nějak oxcat? De to ochcat. Kolega stáhnul popis protokolu získaný reverzním inženýringem (proč to dělat, když už je to hotový, že???) a porovnáním se zdrojovým kódem linuxového klienta sme zjistili, že velikost nasdíleného místa si nezjišťuje server, ale nýbrž posílá ho klient serveru po přihlášení. No a tady už stačí jen maličko, abyste k posílaný hodnotě připočetli třeba 50GB a woaláááá... :-))) No, a paxem si přečet dokumentaci a zjistil sem, že můj klient má tu volbu již naprogramovanou, takže si zadam při spuštění offset, kterej se má připočítat a woalááá... To je jasnej důkaz, že občas se vyplatí si dokumentaci přečíšt, ale zase aspoň vím, jak ten softík funguje.... ehehe... :))) Fakt to vypadá složitě, ale stačej na to nějaký elementární znalosti a paxi říkáte (což mám ouplně nejradši) "Kurwa, to je ňáký podezřele jednoduchý. To mám radost." Prostě nic není tak složitý, aby to opravdu bylo složitý... :-))
Sem se chtěl teďka povýšeně nazvat hax()rem, jenže nemůžu. Protože podle duchovního otce Haxorů JXD, haxorem může bejt inteligentní, nezávislej hulič ve věku 10 až 11 let... eee kurwa, omlouwám se, 17-25 let, takže jsem už moc starej, abych se tak nazýval. Jenže mě to nesere, protože nejsem hax()r, ale nýbrž hacker... :-))))))))))))))))))
No, tak to byla fcelku takowá humorná, krvavě rudá, vložka. Prostě, i já mám svý dny... :)))
Fčera sem si řek, že už se blíží čas, kdy bych měl konečně začít shánět (z povinnosti dárky qánocům). Táxem se vydal do města (naprosto nezhulenej) a vlez do prvního obchodu. Ve chvíli, kdy jsem si uvědomil tu neskutečnou koncentraci lidské hmoty a tu neskutečně přiblblou vánoční atmosféru, táxem tím šopem proplul na vlně nenávisti a vzteku, vyšel ven a zamíříl k nádraží. Už spokojenější, protože sem se nechtěl účastnit vánočního magoření.....
Its ól. Aj hef work..... :))) šit
| 21.12.2001 |
10:25 - ZASRANÝ, ZASRANÝ, ZASRANÝ WÁNOCE PŘICHÁZEJÍ |
Tož dneska to bude jen stručně. Xvátám, xvátám, nemám xvíli klid. Začínaj vánoce a mě dowolená, takže apdejtowat budu from domof, a jen když se mi bude xtít. Konečně sem nakoupil dárky. Sem spokojenější a budu i zhulenější. Tož na závěr jeden hustej zážitek.
Fčera sem šel na nádraží a potkal jsem cestou chlapa se psem. Chlapík, klasickej teplákovej idiot. Modrá šusťáková kombinéza, řekl bych že origonální vjetnamská, s nápisama Adidas. Pes na vodítku byl pudl. Takowej ten hnusnej, popelavě šedivej s mega hustým sestřihem. Ten pes měl obleček. Modrej, šusťákově teplákovej. Na hřbetu zip. Milej pes, měl pod vocasem díru pro prdel (asi aby si nesral do kalhot). Na levý a pravý pulce řiti se mu blištěly přišitý dvě bílý cedulky s červeným nápisem Adidas. Celou cestu sem pak nechápavě kroutil hlavou....
Takže its všechno. Za xvíli jedu do Prahy, tak Vám přeju co nejsfetovanější vánoce a silvestr, co nejčistší drogový substance a vyserte se na všechny ty přání....
| 24.12.2001 |
20:37 - ORGASMUS |
Tak, vánoční šílenství dosáhlo vrcholu. Orgasmus. To napětí, stres, těla v křečích, slastný vzdychání je u konce. Výstřik. Do tmy.
Ulice se vylidnily, v oknech blikaj žárovky a z oken raší vánoční slast. Modře blikající televizní obrazovky kopulují se svými diváky rok co rok stejnými filmy, stejnými pohádkami, šíleně smutnejma princeznama, andělama na hovno, přiblblejma čertama. Padá sníh.
Jak je to město krásný, bez lidí. Hromady sněhu, díky kterým mi pod oknem neparkujou auta, jsem prost ranních startování aut. Sem tam je slyšet dupnutí na brzdy v uklouzaný zatáčce. Jsem v bezpečí, protože bydlím v prvním patře. Žárovky svítěj. Co je to domácí štěstí?
Blbej pořad v týfce co dávaj každou neděli v pravý poledne. Příprava na orgie probíhala už dlouho. Pořádná masáž, nejtvrdší erotická předehra v dějinách lidstva. Dlouhá jako smrt na kříži. Počínající již několik měsíců před samotným aktem. Lásky? Vzrušení se zvyšuje úměrně množství lidí přidávající se k dráždění. Několik dnu předem jsou na vrcholu. Napětí v organismu uvolňujou přehnanou aktivitou, čistění, luxování, umejt psa, zabít kapra, nakoupit jídlo na tři dny. Tolik krve.
Ukájíme se nejbrutánlějším způsobem. Kolik krve je prolito? Kolik krve odteklo kanálama do čističek? Jdu městem a mám pocit, že procházím zahradou smrti. Večer poznám místa, kde se zabíjelo. Červené skrny vsáklé do ledu a sněhu. Lidé čekající frontu na smrt. Každý si zaplatí za to, že se může podívat na smrt tvora. A ještě si ho můžete vybrat. Za peníze si někoho vyberete, pouhým ukázáním odsoudíte k smrti. Červené stoly, od krve zasvinění řezníci. Doma si pak pochutnáte a připojíte slast zabití k celkovému pocitu. Oslavy smrtí.
Večer přijde Ježíšek. Vleze si do bytu potichu a nenápadně. Jako zloděj. A nadělí. Potichu, není vidět, pořád se skrývá hajzlík jeden. Tu je za skříní, tu zase za stolem. Prý Ježíšek není, prý jsou to naši rodiče a nejbližší. Ale nezdá se vám to trochu divný? Jak můžou vaši nejbližší vědět co si přejete? Nejsou přeci vševědoucí, protože kdyby byli, každý by mohl být bohem. Ale to není. Proto dárky nosí Ježíšek, i když nezván, něco přinese. Tu trochu vůně, tu něco látek, tu jen mizernou náladu a nebo štěstí. Mušku zlatou.
Večer půjdeme do kostela. Slušnej člověk dneska nikam nechvátá. Slušnej člověk se přeci nebude v tomhle zasraným počasí srát někam do hajzlu. Radši se pomocí zrakových nervů nakonektnou do virtuálních chrámů a poslouchaj kázání virtuálního kazatele. Nakazit je virem.
Zejtra to bude v pohodě. Bude se vyspávat, protože noc byla dlouhá a orgasmus neodpovídal vynaloženému úsilí. Ó, jak byl krátký a nudný. Taxme poseděli, popili, popřáli si veselý vánoce a hodně štěstí do budoucna, abysme se pak celej rok utápěli v blbý náladě a říkali si "kurwa, já se tak netěším přístí rok na shánění dárků". Stejně do toho zase pudu.
Sláva Satanovi
Jo, aby se neřeklo, že nikdo ode mne nic nedostal, taxi stáhněte nějaký čtení.
Bůh nadělil mi darů,
já ve své zaslepenosti si jich nevážil.
Jak dary odchazejí,
já uvědomuju si jich.
Díky českým drahám sem dneska strávil příjemnou hodinku a půl na velmi hnusném nádraží v Kolíně. Bavil sem se pozorováním smažek, autopotahů a jiných xixtů jedoucí na/z párty. Fakt nechápu co je baví na tom vypadat tak dětinsky, s plyšákama, červenejma kalhotama a pokemonama na zádech.
Jinaxem zase přežranej chlebíčkama, cukrovím a fšelijakejma jinejma vánočníma pochutinama... :-))) To se zase jednou pořádně poseru... :-))
| 27.12.2001 |
17:53 - #@@#$%@@#$% |
Hustý dny. Fčera sem byl na slezině s lidma z gymplu. Jó, po těch sedmi letech (no skoro osmi) od maturity se měněj ouplně neskutečně. Musel jsem si první dvě hodiny vyslechnout vyprávění o problémech se získáváním hypoték, novejch kuchyních, dlaždičkách do chodeb a tak dál. Samozřejmě, že sem to hnedka zezačátku odsoudil jako nesmyslné, nudné a pro mě nezajmavé (abych asi o štyri hodiny později nezačal podobnou debatu já osobně, protože se mě kurwa tenhle problém taky tejká). Prohlížel sem si rodiné fotky svých spolužáků, zvláště ty které mapují život jejich malých dětí. Celkem zajmavý, na první fotce byl obvykle červenej kus masa s nápisem "Danuška jeden stará" a podobně. Spolužačka donesla snad celou tašku fotoalbumů s obrázkama svejch dvou dětí. Přičemž je má snad jen asi tři roky, dokázala vyfotit snad milijón filmů.
Jediný oživení celý ty akce bylo mejch pjet pif a tří džojntů a příchod Kamily, jež se taky vytasila s fotoalbumem (takový malý na pár fotek). A musím přiznat, že s opravdu vynikajícím a naprosto originálním. Sem ho otevřel a hnedka se na mě zazubilo nějaký malý dítě. Taxem se jako podíval na Kamilu, abych se dozvěděl, že je to sestřenice. A pak to vypuklo na plno. Otočil sem list a ocitl se v jiným světě. Fotografie Petriho misek s různejma rudejma a tmavě červenejma (až černejma) sqrnama. Stafilokoky, enterokoky a všelijaký jiný koky. Okamžitě jsem se zeptal (původně teda z prdele) "jaxou starý" a na to sem dostal přednášku, že tyhle 12 hodin, tomuhle zase štyriadvacet. (jo kurwa, teďka sem si vzpomněl, že sem ty fotky dostal asi před půl rokem mejlem...)
Posilam obrazky enterokoku.
- na pude Slanetz-Bartley (01186151,07185172)
- na krevnim agaru
- na zluc-eskulin-azidovem agaru
Ale co je co, to fakt teda newim....
Faktem je, že takový vyrušení ze fšední sešlosti mě dycky potěší. Jo, a paxe zase tlachalo. Mé pozvání na špeka se skoro(!) nedočkalo odezvy, i když vím, že některý lidi si občas daj. No nevím proč to bylo, asi tím, že sou vánoce a všichni ještě sjížděj příbuzný. I když já sjíždím i rodiče občas mírně přihouklej. :-) Jo, taky sem se dozvěděl, že ouplně shodou okolností bude kámoška makat ve stejným baráku jako já, akorát asi o dvě poschodí níž. Což mě opravdu pobavilo jaxvině. Svět je dycky plnej přeqapení.... :-)
Jinaxem si dneska jel koupit kalhoty. Kurwa, jak já nesnáším chození po šopech s hadrama. Nakonec sem koupil manžestráky u kenwela (nebo tak ňák), ale hráli tam fakt zasraně hnusnou muziku, snad nejhnušnější jakou sem kdy v poslední době slyšel. No, prostě byl sem celý odpoledne zpruzenej, nóó...
Vo wejkendu sem byl v Praze, bylo to hustý, fakt megahustý. Byl to takowej hodně zvláštní trip. Fakt newím, co si mám o některejch lidech a věcech myslet. Ale myslím, že si to asi nechám pro sebe, protože když to hulení tak posouvá vnímání tak parádně mimo realitu, že budu muset počkat na setkání (nedejbože) za "střízliva". Každopádně, dostal jsem konopnou mastičku, takže ji v rámci experimentu vyzkouším na mém bratrovi, kterej není dotčenej zbožněním konopí, a když mu pomůže, tak uvěřím... :-) Ale stejne marihuána může vyléčit rakovinu, to mi nikdo nevymluví.... :-)) Hlavně pravidelný kouření je na to nejlepší.... :-)
No a ještě se dostanu k dnešnímu tisku. Konečně vyšli zase tištěný noviny. Taxem si přečet Mladou Frontu Dnes, a pobavil mě v ní článek, tuším od Mirky Spáčilový, kde si vylejvá svoje city na vánoční televizní přehlídku. No, mezi náma, byla fakt hnusná, teda aspoň z toho mála co sem viděl (kdybych tvrdil, že sem se na týfku vůbec nekoukal, tak to bych lhal). Jenže tahle dotyčná paní napsala článek snad přes půl stránky, kde líčila snad všechny pořady, který byly během vánočních svátků na ČT1 a TV Nova, skoro každej vyprudila, jakej byl trapnej (hlawně zábavné pořady a Peříčko). Přičemž na konci jako obvykle došla TV Nova zaslouženého odsouzení. No, a mě tak napadlo, esli se dotyčná autorka celý vánoce válela u televize s dálkovým wowládáním a přepínala programy z jednoho kanálu na druhý, nebo esli jen pročetla televizní programy a jako správná intelektuálka prostě obligátně zavrhla (zvláště vše na komerční vizi). Jenže je v tom jistej (a celkem jasnej rozpor), protože kdyby chtěla napsat objektivní reportáž, tak by fakt celý ty dny seděla u týfku, srala na děti a jen čuměla na bednu. Jenže to správnej intelektuál nedělá (kurwa, koukat na týfku je tak barbarské - a zwláště ty americký filmy - sou některý kurwa tak dobrý...), ale pak by zase nemohla napsat objektivní článek. to je, kurwa blbá úvaha....... A točíme se v kruhu...
No, když už sme u toho Peříčka. Fčera, když sem přišel z tý párty, taxem zrowna chytil kousek, kde byl pozvanej Richard Muller (snad se tak píše). Když sem ho tak chvíli poslouchal, taxem si říkal esli je nebo nejní na piku. Ale byl celkem otevřenej víc než se lidi otevřou, a nebo je to kurwa pohodář jaxvině, ale jen lidi si myslej, že fetuje... :))
Možná, že si někdo všimnul, že zapomínám písmenka. Celkem pravděpodobně je to qůli dyslexii. Předškolní doktoři a doktorky sou pjekný kokoti. Furt samá kontrola, esli se vyvíjim dobře, furt ňáký testy esli můžu do první třídy. No normálně, prej sem na tom byl tak blbě, že když sem šel dělat ty testy, jako jestli sem způsobilej jít do tý první třídy, že sem je málem neudělal. Jediná klika, že matka ty testy někde sehnala, taxem doma trénoval jaxvině. Kreslil sem panáčka, psal slovo Ema a ještě ňákou kravinu.
Takže sem došel ke zjištění, že život člověka už od narození prochází různejma testama, který si na něj připravili jiný lidi. Snad, aby odfiltrovali divný jedince??? Když sem se narodil, ještě mi nebyl ani den, a už mám zápis o testu. V tom (papíru, kterej sem viděl předefčírem poprvý od narození) jsou štyři číslice 9,9,10 a 10. A prej mezi 36-40 je dítě ouplně normální. Nepodařilo se mi zjistit, co to ty čísla znamenaj, ale jedno z nich je prej snad kvalita kůže a esli má dítě zdrawý plíce (jako, že křičí). Tož sem od začátku života naprosto hustej průměrnej jedinec. Ale fakt brutálně. Což se mi ukázalo, když sem si nechal dělat na gymplu IQ testy. Teda řeknu, je to stresující, když nevíte co vám vyleze, když zaškrtáváte nějaký obrázky nebo šslova, který někam nepatřej. Prostě test na dvě hodiny. Asi po štrnácti dnech přijeli borci z tý worganizace co to páchala, každýho si pozvala na pokec, kde mu ukázali výsledek (tj. číslo). Mě vyhodnotili na 112 (a paradoxně, o jeden stupeň více, než měla nejlepší studentka ze třídy :-) a řekli mi, že je to naprostej hustej průměr, že prej normalita je někde mezi 96-130 (tuším, což neznamená, že se u nás nevyskytli jedinci s hodnotama jako 125 nebo 132 (čaf Martine... ;-)). Pak na mě vytáhli nějaký čárový grafy, kde sem měl štyri naprosto rovný čáry u kterej bylo napsáno humanitní, technické, a já ještě nevím co. A dotyčná paní mi říkala, že to ještě nikdy v životě neviděla. Prostě to mělo symbolizowat schopnosti na různý obory. Ale když sem pak viděl grafy spolužáků, tak každej tam měl strašně strmý výkyvy, buď údolí jaxvině a nebo hustý kopce. Je mi jasný, že tyhle IQ testy sou ouplně na howno, že naprosto nemaj žádnou vypovídací hodnotu, ale kurwa, když se nad tím tak zamyslím, tak podle Gausovy křivky, bych asi ležel někde ouplně na špici, naprosto na polovině mezi šílencema a gényjama. Kurwa, to je ale hustý........
Vysvětlit a omluvit se dá všechno, ale mě zaráží, jak člověk během svýho života prochází jen samejma testama. Pořád sem na něco testowanej. Možná, že ani o některejch testech ani nevim, a někde v ňáký laboratoři z mejch buněk klonujou nějakou chiméru. Jo, a ty buňky by mohli ukrást třeba v holičství, kde si nechávám stříhat vlasy. Agenti zasraný.....
Poslední test nejpíš "prožiju" v márnici, kde opravdu dobře mířeným řezem zjistěj, esli sem fakt skutečně mrtvej. No, možná ještě kouř projde nějakým čistícím zařízením a wotestujou si, esli nejsem toxickej. Abych neotrávil spoluobčanům vzduch.
Jóó, a zase sem naštěstí neviděl Samotáře. Kurwa, já sem tak šťastnej, po tý akci v týfce, nás (co sme je neviděli) bude kurwa málo. Což mi připomíná, že sem slyšel dvě historky bořící kulty. Za prvý, chlapík co hrál v Návratu Idiota (P. Liška - či jaxe to...), je prej hroznej kretén, kterej si nechává rád pochlebovat od ňákejch dvou týpků. Za druhý, Macháček ze Samotářů prej skoro (nebo vůbec) nehulí, a defakto je fakt jen kurwa dobrej herec.... :-) Co je na tom prafdy newím, sou to jen drby, ale na každým šrotu, prafdy trochu...... :-)
| 28.12.2001 |
17:49 - Moje taje sníh |
Konečně pátek. Zejtra mizím z civilizace. Až do prvního ledna nového roku.
Takže dnešek tomu odpovídal. Prolenošenej den. Přečet sem hromadu tisku, skouknul zprávy, habych se dozvěděl whaz ňů a dobře se najedl. A právě teď sem si uvědomil, že se mi do tašky nevejde hajzl papír. Holt budu počítat s tím, že na xatě ňákej máme. Jinak budu srát do sněhu. Kdyby to někoho zajmalo, tak jedu do Ledečka, kousek wod Ratají nad Sázavou. Je to tam celkem príma, i když si myslím, že tam bude na silwestra stalona pěknej nával. Ale na to seru. Nezúčastním se šílenství. Kromě hulení, s žádnejma drogama nepočítám, ne že bych nechtěl, ale nesehnal sem to co sem chtěl. :-) Možná je to dobře, aspoň nebudu muset nic řešit.
Takže to znamená, že dlouho nic nenapíšu. Takže, už skoro, jako obvykle aktualizuju kapitolu čtení. Klasicky sou to zase ňáký uchyláci co psali wo drogách.
Taxi říkám, že už se na to vyseru a pudu si číst.
|